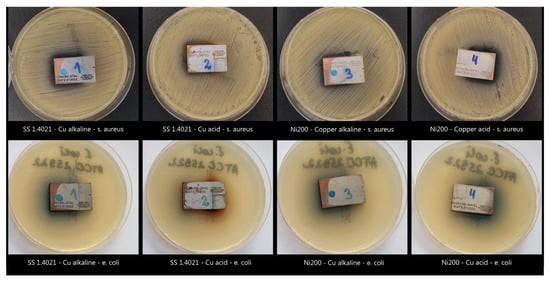

Abstract
This study presents a preliminary characterization of selective plated antibacterial copper coatings on medical-grade stainless steel 1.4021 and nickel alloy Ni200 substrates using two different copper electrolyte solutions with acidic and alkaline pH. The characterizations included analysis of the microstructure, phase composition, surface roughness, and antibacterial activity against Gram-positive Staphylococcus aureus ATCC 29213 and Gram-negative Escherichia coli ATCC 25922 bacteria. The results revealed uniform and continuous layers of single-phase solid-solution copper coatings without any cracks or defects. The coatings, produced using acidic or alkaline solutions, exhibited approximately 20% or 40% lower surface roughness compared to the substrate roughness. This suggests that the plating process led to a smoother surface finish. Importantly, all of the selective plated copper coatings exhibited antibacterial properties. Inhibition zones were identified, indicating the ability of the coatings to inhibit the growth of both Gram-positive Staphylococcus aureus and Gram-negative Escherichia coli bacteria. The use of the alkaline copper solution resulted in slightly larger inhibition zones compared to the acidic solution, indicating enhanced antibacterial activity. These findings suggest that the selective plated copper coatings on medical-grade stainless steel 1.4021 and nickel alloy Ni200 substrates have the potential to be effective antibacterial surfaces.
1. Introduction
Bacterial infections associated with implanted orthopaedic devices can have severe consequences, as they have the potential to delay or even stop bone fracture healing processes and hinder the successful implant osseointegration in the human body []. The risk of nosocomial infections—which refers to infection diseases acquired during a hospital stay—is an existing concern for all surgical patients, being particularly critical for those who receive implanted devices []. Over recent decades, a large number of publications and extensive reports, issued by such reputable sources as the World Health Organization (WHO), have shed light on the alarming extent of nosocomial infections, revealing that the problem is not only substantial but also on the rise [,,,].
Despite the implementation of standardized protective measures in the majority of healthcare facilities, the threat of infections persists; they are frequently attributed to commensal bacteria residing on the skin of patients and/or healthcare personnel []. These bacteria, typically coexisting harmlessly with the human body, have the potential to survive on the skin and other surfaces for extended periods of time, serving as a reservoir for infection []. Furthermore, the extensive use of antibiotics in healthcare settings can contribute to the emergence of antibiotic resistant strains, making these bacteria even more challenging to treat when they cause an infection []. The treatment of antibiotic-resistant infections often causes difficulties and, in some cases, becomes impossible, underscoring the urgent need for innovative approaches. It is evident that novel measures are necessary to combat these persistent threats and enhance infection prevention and control strategies in healthcare environments [].
Most commonly, the methods for disinfection of surfaces employed by health care providers involve the use of volatile chemical compounds such as aldehydes (glutaraldehyde and formaldehyde), hydrogen peroxide, chlorine dioxide, and ethylene oxide. While these compounds exhibit immediate antibacterial activity upon contact with contaminants, they have a tendency to evaporate quickly, leading to a loss of effectiveness [,]. Furthermore, previous research work [,] has highlighted the potential hazards associated with the frequent use of such cleaning and disinfecting agents, particularly their detrimental effects on the respiratory system of healthcare personnel and patients. This poses a significant challenge for medical care facilities, as the reliance on traditional disinfection approaches may not be sustainable in the near future. Therefore, there is a pressing need for development and implementation of new strategies that are both reliable and safe to address the limitations and risks associated with current practices [].
The antibacterial properties of copper have been recognized and utilized for centuries. Historical records indicate that copper was employed for sterilizing drinking water and treating wounds, dating back to some of the oldest writings []. Throughout the history of mankind, various civilizations have effectively utilized copper as an antibacterial agent [,]. In modern times, it is understood that the antibacterial activity of copper is closely associated with its high electrochemical potential, which enables it to easily donate and receive electrons. Microorganisms such as bacteria utilize copper-containing enzymes in many in vivo processes and chemical reactions such as electron transfer and oxidative phosphorylation. Additionally, copper ions play a crucial role in the formation of disulfide bonds in proteins, which is essential for their structural integrity and proper functioning. The deep-rooted and multifaceted antibacterial properties of copper make it an intriguing and valuable option for combating bacterial infections in various applications.
However, it is important to note that copper can also be toxic when excessive amounts of it are introduced to bacteria. In this context, the bacterial interaction with copper involves two primary stages. In the first stage, copper ions (Cu2+) react with lipids to oxidize them and open channels in the cell membrane. This causes a rapid decrease in the integrity of the cell membrane, followed by its rupture and outflow of intracellular substances, e.g., potassium ions. In the second stage, a reactive hydroxyl radical (OH·) is formed as a result of the redox reaction, strongly affecting the DNA and disrupting the metabolism of proteins, lipids, and respiration, leading to cell death and consequently/ultimately to the disintegration of the bacteria [,,,]. In addition, other forms of copper, such as copper nanoparticles or copper oxide, can also exhibit antibacterial properties through different mechanisms [,]. This antibacterial activity is with a broad spectrum, in that it may act against a broad range of potential pathogens and is much less selective than other approaches, such as the use of antibiotics. Considering these inherent properties, the application of copper coatings on various metallic substrates may be considered a promising, long-lasting, and economically effective antibacterial solution.
Therefore, the objective of this study was to investigate the antibacterial characteristics, surface roughness, microstructure, and phase composition of selective plated copper coatings. By examining these aspects, we aimed to gain a comprehensive understanding of the performance and potential applications of these coatings in inhibiting bacterial growth and providing enhanced antibacterial properties.
2. Materials and Methods
Selective plated copper coatings were meticulously deposited on two types of metallic substrates made of either medical-grade stainless steel (SS) 1.4021 or nickel alloy Ni200. The substrates were cut to dimensions of 20 mm × 30 mm × 3 mm from sheets using wire electro-cutting. The dimensions were provided by a surgical instruments manufacturer (Chirmed, Rudniki, Poland). Following the cut-out process, the steel substrates were submitted to heat treatment, performed to relieve stresses. Finally, the surfaces of the substrates were finished using peening with glass micro-beads of gradation 40–70 µm. These well-defined and standardized procedures were implemented to ensure consistent and reliable samples for further investigation and analysis.
During the selective plating process, two types of copper electrolyte solutions—acidic and alkaline—were used. Prior to initiating the copper-plating process, a series of preparatory operations were performed. These included substrate masking, specific preparatory steps depending on the substrate material, and application of a bonding layer. First, a rectangular area of 20 mm × 25 mm (500 mm2) was carefully masked on the surface of each substrate. The preparatory steps for both stainless steel and nickel alloy substrates included electrochemical cleaning, electrochemical etching, and activating the masked surface. Following this, a bonding nickel layer of 1 μm thickness was deposited via selective plating. While the presence of such a layer is in favor of the adhesive strength, it simultaneously serves as a hydrogen and oxidation barrier. Finally, a copper layer of 40 μm thickness of was plated onto the surfaces. Immediately after the plating procedure, all samples were thoroughly rinsed with deionized water and carefully dried to ensure their readiness for subsequent analysis and evaluation.
All utilized chemical reagents, purchased from Marvin Ltd. (Varna, Bulgaria), were of analytical grade quality, ensuring their reliability and accuracy. Two distinct plating electrolytes were used for copper deposition: an acidic solution with a pH value of 0.5 ± 0.1, and an alkaline solution with a pH value of 8.5 ± 0.1. It is worth noting that all experimental procedures were meticulously carried out under conditions of a controlled laboratory environment. The solutions were maintained at a constant temperature of 20 °C ± 1 °C throughout the selective plating process. The setup configuration for selective plating is illustrated schematically in Figure 1.

Figure 1.
Schematic illustration of the selective plating process (left) and a plated sample (right).
In order to thoroughly assess and analyze the properties of the coatings, a comprehensive range of characterization techniques was employed. The microstructure and thickness of the coatings were investigated using an upright metallurgical microscope equipped with a digital camera and dedicated software (LM-308, L&D, DGT-SRT200A, Dandong, China). Cross-sections of the plated samples (including substrates) were created using a low-speed cutting machine (DTQ-5, LaiZhou Weiyi Experimental Machinery Manufacture Co., Yantai, China). All samples used for optical microscopy were molded in black resin, grinded with alumina sandpaper, and polished with diamond suspension.
X-ray diffraction (XRD) analysis was carried out to evaluate the phase composition of the plated layers using a diffractometer (D8 Discover, Bruker, Billerica, MA, USA) with CoKα radiation (λ = 1.79026 Å) at room temperature. The XRD patterns were collected in 2-Theta coupled mode in the range 20–138°, identifying and matching the peaks utilizing XRD analysis software (X’pert HighScore Plus, PANalytical B.V., Almelo, The Netherlands). The surface roughness of both the substrates and copper coatings, quantified as the arithmetic mean roughness (Ra), was assessed using a profilometer (DGT-SRT200A, Baxit, Shanghai, China). Each sample underwent five independent profile measurements to ensure reliable and representative data.
To evaluate the antibacterial effectiveness of the selective plated copper coatings, a series of microbiological tests were conducted using Gram-positive Staphylococcus aureus ATCC 29213 (S. aureus) and Gram-negative Escherichia coli ATCC 25922 (E. coli) utilizing the inhibition zone method in a specialized microbiological laboratory. Prior to the microbiological tests, the samples’ surfaces underwent a rigorous cleaning process using 70% ethyl alcohol. This step was crucial to eliminate any microbial contaminants that could potentially interfere with the test results and compromise their accuracy. Furthermore, the cleaned samples were exposed to ultraviolet (UV) irradiation at a wavelength of 253.7 nm for 30 min. The UV exposure served as an additional measure to ensure the sterility of the sample surfaces. By implementing these rigorous cleaning and sterilization protocols, the integrity and reliability of the microbiological test results were upheld.
To initiate bacterial cultures, both strains were inoculated into flasks containing nutrient broth (NB) and incubated at 37 °C under aerated conditions until the bacterial cultures reached an optical density of 0.5 McF, corresponding to 1.5 × 108 colony-forming units per milliliter (CFU/mL). The inoculum was plated on Mueller–Hinton (MH) agar, and the resulting inhibition zones surrounding each coating were analyzed using the Kirby–Bauer method []—a standard practice for assessing antibacterial susceptibility in microbiology. The selective plated copper coatings were placed on the inoculated agar plates, and the entire setup was incubated at 37 °C for 24 h. The presence of clear zones around the selective plated samples indicated the presence of antibacterial activity, suggesting that the copper coatings exhibited inhibitory effects on the growth of the bacteria. Following the completion of the testing procedure, a sterilization cycle was carried out to assess the behavior of the coatings under standard sterilization conditions.
3. Results
3.1. Microstructure
Figure 2 provides a visual presentation of the microstructure of the selective plated copper coatings. Uniform and continuous deposits were formed without detected cracks or defects on their surfaces. Similarly, upon examining the cross-sections of the samples, no defects were detected within the coatings, indicating a consistent and well-formed structure.

Figure 2.
Optical micrographs of the substrates of medical-grade stainless steel (SS 1.4021) and nickel alloy (Ni200) selective plated with either alkaline (Cu alkaline) or acidic (Cu acid) electrolyte solutions: coating surface (top) and cross-section (bottom) views.
The measured thickness of the coatings was 40 ± 2 μm (mean thickness ± standard deviation), accounting for any variations. This thickness closely aligned with the anticipated values calculated prior to plating, affirming the accuracy of the selective plating process using both the acidic and alkaline electrolyte solutions on both stainless steel and nickel alloy substrate materials. These results indicate the successful formation of high-quality copper coatings on both substrate materials, fulfilling the objective of the plating process.
3.2. Phase Analysis
The X-ray diffraction (XRD) patterns presented in Figure 3 provide valuable insights into the crystal structure of the selective plated copper coatings created using both the acidic and alkaline electrolyte solutions. The patterns exhibited well-defined diffraction peaks corresponding to specific copper crystal planes, which were successfully indexed and matched with the cubic Cu crystal structure. These findings align well with the information provided by the JCPDS copper file number 04-0836, further validating the composition and crystal structure of the coatings.

Figure 3.
X-ray diffraction patterns of the selective copper coatings using either acidic (red) or alkaline (blue) electrolyte solutions.
For a more detailed characterization, peak parameters derived from the XRD profiles can be found in Table 1 and Table 2. These parameters provide information about the peak positions, peak intensities, and peak widths, contributing to a more comprehensive understanding of the copper coatings’ crystallographic properties.

Table 1.
Peak parameters in terms of intensity, distance between the crystallographic planes (d-Spacing), angle between the transmitted and reflective beam (2Theta), Miller indices of the crystallographic plane (HKL), and full width at half maximum of the peak (FWHM) derived from the diffractogram obtained from the selective plated copper coatings using Cu acid solution.

Table 2.
Peak parameters in terms of intensity, distance between the crystallographic planes (d-Spacing), angle between the transmitted and reflective beam (2Theta), Miller indices of the crystallographic plane (HKL), and full width at half maximum of the peak (FWHM) derived from the diffractogram obtained from the selective plated copper coatings using Cu alkaline solution.
Overall, the XRD analysis confirmed the formation of a single-phase solid solution of pure copper in the selective plated coatings, regardless of the substrate material and electrolyte used, highlighting their consistency and quality.
3.3. Surface Roughness
The measured average surface roughness Ra of the as-received substrates and selective plated copper coatings deposited on them using either Cu acid or Cu alkaline electrolyte solutions is illustrated in Figure 4.

Figure 4.
Surface roughness Ra of the as-received medical-grade stainless steel (SS 1.4021) and nickel alloy (Ni200) substrates (initial), and of the selective plated copper coatings deposited on them using either Cu acid or Cu alkaline electrolyte solutions.
For the stainless steel substrates, the initially measured average surface roughness was 1.463 ± 0.450 µm. After the deposition of copper coatings using the acidic electrolyte solution, the roughness decreased to 1.173 ± 0.430 µm. Similarly, when the alkaline electrolyte solution was used, the roughness further decreased to 0.857 ± 0.190 µm. These results indicate a reduction in surface roughness after the selective copper-plating process on stainless steel substrates, regardless of the electrolyte solution employed.
In the case of nickel alloy substrates, the initially measured average surface roughness was 4.178 ± 0.490 µm. Following the deposition of copper coatings using the acidic electrolyte solution, the roughness decreased to 3.406 ± 0.330 µm. When the alkaline electrolyte solution was used, the roughness further decreased to 2.601 ± 0.680 µm. These findings demonstrate a considerable reduction in surface roughness after the selective copper-plating process on nickel alloy substrates, regardless of the electrolyte solution utilized.
The obtained results indicate that the selective plated copper coatings effectively reduce the surface roughness of both stainless steel and nickel alloy substrates. This reduction in roughness can have implications for improving the surface properties of the coated materials, such as reducing the potential for bacterial adhesion.
3.4. Antibacterial Activity of Selective Plated Copper Coatings against S. aureus and E. coli
Figure 5 illustrates the inhibition zones (ZOI) formed around the selective plated copper coatings on stainless steel 1.4021 and nickel alloy Ni200 substrates after 24 h of incubation at 37 °C. The ZOI represents the area surrounding the copper-plated region where bacterial growth is inhibited. It is evident that the ZOI is formed around the copper-plated area but not on the substrate material itself. This suggests that the copper coatings exhibit antibacterial activity, preventing the growth of bacteria in the vicinity of the coated regions.
Figure 5.
Antibacterial activity of selective plated copper coatings using either acidic (Cu acid) or alkaline (Cu alkaline) electrolyte solutions on medical-grade stainless steel (SS 1.4021) and nickel alloy (Ni200) samples against S. aureus (top row) and E. coli (bottom row) after 24 h incubation at 37 °C.
Furthermore, Figure 6 highlights that the visible ZOI formed after the incubation period are more pronounced in the samples exposed to Gram-positive (S. aureus) versus Gram-negative (E. coli) bacteria. This indicates that the copper coatings have a stronger inhibitory effect on the growth of Gram-positive bacteria compared to Gram-negative bacteria.

Figure 6.
Highlighted extents of the inhibition zones (green) surround the selective plated samples using either acidic (Cu acid) or alkaline (Cu alkaline) electrolyte solutions on medical-grade stainless steel (SS 1.4021) and nickel alloy (Ni200) samples against S. aureus (top row) and E. coli (bottom row) after 24 h incubation at 37 °C.
The formation of inhibition zones around the copper-plated areas confirms the antibacterial properties of the selective plated copper coatings. This observation supports the potential of these coatings as effective measures to reduce bacterial colonization and prevent infections associated with medical devices or other applications where antibacterial properties are desired.
The average area of the inhibition zones formed around the copper coatings deposited from the alkaline solution and tested with S. aureus and E. coli was approximately 1250 mm2 and 1050 mm2, respectively. On the other hand, the inhibition zones formed around the coatings deposited from the acidic copper solution were slightly smaller, with an average area of 1050 mm2 and 950 mm2 when tested with S. aureus and E. coli, respectively. These results indicate that the selective plated copper coatings demonstrated biocidal activity against both S. aureus and E. coli.
Interestingly, the surface roughness of the copper coatings did not significantly affect their antibacterial activity against both tested strains of bacteria. Regardless of the different surface roughness of the selective plated copper coatings on stainless steel 1.4021 and nickel alloy Ni200 substrates, the coatings retained their bioactive resistance against both Gram-positive S. aureus and Gram-negative E. coli. This suggests that the antibacterial properties of the copper coatings are not heavily influenced by surface roughness.
Figure 6 further demonstrates that the area of the inhibition zones formed around the copper coatings is relatively similar for both tested bacteria, irrespective of the variations in surface roughness. This indicates that the selective plated copper coatings maintain consistent antibacterial efficacy against different types of bacteria, regardless of the surface characteristics.
Overall, these findings highlight the promising antibacterial activity of the selective plated copper coatings and their potential as effective measures for inhibiting bacterial growth and preventing infections. The coatings demonstrated biocidal effects against both Gram-positive and Gram-negative bacteria, and the surface roughness did not considerably impact their antibacterial performance.
4. Discussion
This study introduces a novel approach to the selective plating of copper coatings on medical-grade stainless steel 1.4021 and nickel alloy Ni200 substrate materials. These materials are commonly used for production of surgical instruments, e.g., forceps/tweezers. Selective plating offers several distinct advantages over traditional plating methods []. First, it provides a highly targeted and localized plating approach, allowing for precise and controlled deposition of coatings on specific areas or components of a workpiece. This selective nature eliminates the need for extensive masking or complex setups typically required for other plating methods, thereby saving time and reducing material waste. Furthermore, the selective plating allows for easy control and adjustment of the plating parameters such as current density and solution composition, facilitating customization of coating thickness, composition, and other characteristics according to specific requirements [,].
For the purpose of this study, a precalculated selective plating regime was set to achieve a copper coating with a targeted thickness of 40 μm. This precalculated value served as a guideline to achieve the desired thickness during the plating process. The actual thickness of the coatings obtained in the study was 40 ± 2 μm. The close agreement between the targeted and actual coating thickness confirms the accuracy and precision of the selective plating method employed in this work. The ability to consistently obtain a desired coating thickness is crucial for ensuring the functional and protective characteristics of the coatings. In applications where a specific coating thickness is required for optimal performance, the ability to accurately control the plating process and achieve a desired thickness is of great importance [,]. Overall, the close agreement between the targeted and measured coating thickness affirms the effectiveness of the precalculated selective plating regime, providing confidence in the reproducibility and reliability of the plating process.
These XRD analysis and the corresponding evaluated peak parameter provide valuable insights into the crystallographic properties and phase composition of the selective plated copper coatings. The consistent identification of a single-phase pure copper solid solution confirms the successful formation of the desired coatings.
The results related to surface roughness indicate similar patterns observed for its alterations when using both substrate materials this study. Although the initial surface roughness was different for the SS 1.4021 and Ni200 substrates, the surface roughness of the selective plated copper coatings was approximately 80% of the corresponding substrate value when acidic copper solution was used, and nearly 60% when alkaline copper was used for plating on both metallic substrates. Surface roughness is presumably important for the antibacterial properties of the biocidal surfaces as it may increase considerably the active exposure area.
The analysis of the inhibition zones formed around the selective plated copper coatings provides valuable insights into their antibacterial activity. The average area of the inhibition zones varied depending on the type of used copper solution and tested bacteria. However, these results highlight the potential of the selective plated copper coatings as effective antibacterial agents against both Gram-positive and Gram-negative bacteria. The ability of the coatings to exhibit biocidal activity while maintaining their performance across different surface roughness conditions is advantageous for various applications where surface hygiene and bacterial resistance are critical. Further research could delve into the underlying mechanisms responsible for the antibacterial activity of the coatings and explore potential optimizations to enhance their performance even further.
5. Conclusions
The selective plating method described in the current study allows for uniform and continuous deposition of copper coatings on medical-grade stainless steel 1.4021 and nickel alloy Ni200 substrates without presence of cracks or defects. The use of both acidic and alkaline electrolyte solutions enables formation of single-phase solid-solution copper coatings, indicating a high level of coating integrity.
One significant advantage of the selective plating technique is that it can refine the surface roughness of the substrates. The copper coatings produced with the acidic or alkaline solution exhibited surface roughness approximately 20% or 40% finer than that of the substrates, respectively. This reduction in surface roughness can have several benefits, including improved aesthetics, enhanced corrosion resistance, and reduced friction in certain applications.
Importantly, the copper coatings deposited using selective plating demonstrated antibacterial activity. The inhibition zones formed around the coatings indicate their ability to inhibit the growth of bacteria, making them suitable for applications where preventing bacterial contamination is crucial. The use of an alkaline copper solution resulted in slightly larger inhibition zones compared to the acidic solution, suggesting potentially higher antibacterial effectiveness.
These findings highlight the potential of selective plating as a reliable and effective method for deposition of antibacterial copper coatings on stainless steel and nickel alloy substrates. The ability to achieve uniform and continuous coatings without compromising their surface integrity, coupled with their antibacterial properties, makes this technique promising for various applications, including use of surgical instruments, medical devices, and other healthcare-related equipment. Given the promising results obtained, further studies will be undertaken to investigate the long-term stability, compatibility, and specific mechanisms underlying the antibacterial effectiveness of these coatings. Additionally, the applicability of this technique to a wider range of medical-grade materials and its potential integration with other surface modification methods will be explored to enhance its versatility and suitability for diverse healthcare applications.
Author Contributions
Conceptualization, D.V. and H.S.; formal analysis, D.V., H.S., R.Y. and S.I.; investigation, D.V., R.Y. and T.F.M.; supervision, H.S. and B.G.; validation, H.S., R.Y., S.I. and T.F.M.; visualization, D.V.; writing—original draft, D.V.; and writing—review and editing, D.V., H.S., R.Y., S.I., T.F.M. and B.G. All authors have read and agreed to the published version of the manuscript.
Funding
This work was supported by the Bulgarian National Science Fund within the M-ERA.NET Programme, Project “New generation copper based coatings of improved antimicrobial resistance to pathogens”, No. KΠ-06-DO-02/1.
Data Availability Statement
The datasets analyzed during the current study are available from the corresponding author on reasonable request.
Conflicts of Interest
The authors declare no conflict of interest. The funders had no role in the design of the study; in the collection, analyses, or interpretation of data; in the writing of the manuscript; or in the decision to publish the results.
References
- Steinmetz, S.; Wernly, D.; Moerenhout, K.; Trampuz, A.; Borens, O. Infection after Fracture Fixation. EFORT Open Rev. 2019, 4, 468. [Google Scholar] [CrossRef]
- Kennedy, D.G.; O’Mahony, A.M.; Culligan, E.P.; O’Driscoll, C.M.; Ryan, K.B. Strategies to Mitigate and Treat Orthopaedic Device-Associated Infections. Antibiotics 2022, 11, 1822. [Google Scholar] [CrossRef] [PubMed]
- Wolfensberger, A.; Clack, L.; Kuster, S.P.; Passerini, S.; Mody, L.; Chopra, V.; Mann, J.; Sax, H. Transfer of Pathogens to and from Patients, Healthcare Providers, and Medical Devices during Care Activity—A Systematic Review and Meta-Analysis. Infect. Control Hosp. Epidemiol. 2018, 39, 1093–1107. [Google Scholar] [CrossRef]
- Ananda, T.; Modi, A.; Chakraborty, I.; Managuli, V.; Mukhopadhyay, C.; Mazumder, N. Nosocomial Infections and Role of Nanotechnology. Bioengineering 2022, 9, 51. [Google Scholar] [CrossRef]
- Global Report on Infection Prevention and Control. Available online: https://www.who.int/publications/i/item/9789240051164 (accessed on 1 June 2023).
- Report on the Burden of Endemic Health Care-Associated Infection Worldwide. Available online: https://apps.who.int/iris/handle/10665/80135 (accessed on 1 June 2023).
- Revelas, A. Healthcare—Associated Infections: A Public Health Problem. Niger. Med. J. 2012, 53, 59. [Google Scholar] [CrossRef]
- Grice, E.A.; Segre, J.A. The Skin Microbiome. Nat. Rev. Microbiol. 2011, 9, 244–253. [Google Scholar] [CrossRef] [PubMed]
- Chinemerem Nwobodo, D.; Ugwu, M.C.; Oliseloke Anie, C.; Al-Ouqaili, M.T.S.; Chinedu Ikem, J.; Victor Chigozie, U.; Saki, M. Antibiotic Resistance: The Challenges and Some Emerging Strategies for Tackling a Global Menace. J. Clin. Lab. Anal. 2022, 36, e24655. [Google Scholar] [CrossRef]
- Roy, R.; Tiwari, M.; Donelli, G.; Tiwari, V. Strategies for Combating Bacterial Biofilms: A Focus on Anti-Biofilm Agents and Their Mechanisms of Action. Virulence 2018, 9, 522–554. [Google Scholar] [CrossRef] [PubMed]
- Disinfection Methods|Disinfection & Sterilization Guidelines|Guidelines Library|Infection Control|CDC. Available online: https://www.cdc.gov/infectioncontrol/guidelines/disinfection/disinfection-methods/index.html (accessed on 2 August 2023).
- Mcdonnell, G.; Russell, A.D. Antiseptics and Disinfectants: Activity, Action, And. Clin. Microbiol. Rev. 1999, 12, 147. [Google Scholar] [CrossRef]
- Su, F.-C.; Friesen, M.C.; Stefaniak, A.B.; Henneberger, P.K.; LeBouf, R.F.; Stanton, M.L.; Liang, X.; Humann, M.; Virji, M.A. Exposures to Volatile Organic Compounds among Healthcare Workers: Modeling the Effects of Cleaning Tasks and Product Use. Ann. Work. Expo. Health 2018, 62, 852–870. [Google Scholar] [CrossRef] [PubMed]
- Steinemann, A.; Nematollahi, N.; Rismanchi, B.; Goodman, N.; Kolev, S.D. Pandemic Products and Volatile Chemical Emissions. Air Qual. Atmos. Health 2021, 14, 47–53. [Google Scholar] [CrossRef]
- Fischer, F.; Lange, K.; Klose, K.; Greiner, W.; Kraemer, A. Barriers and Strategies in Guideline Implementation—A Scoping Review. Healthcare 2016, 4, 36. [Google Scholar] [CrossRef]
- Grass, G.; Rensing, C. Genes Involved in Copper Homeostasis in Escherichia Coli. J. Bacteriol. 2001, 183, 2145–2147. [Google Scholar] [CrossRef]
- Dollwet, H.; Sorenson, J. Historic Uses of Copper Compounds in Medicine. Trace Elem. Med. 1985, 2, 80–87. [Google Scholar]
- Vincent, M.; Duval, R.E.; Hartemann, P.; Engels-Deutsch, M. Contact Killing and Antimicrobial Properties of Copper. J. Appl. Microbiol. 2018, 124, 1032–1046. [Google Scholar] [CrossRef]
- Giachino, A.; Waldron, K.J. Copper Tolerance in Bacteria Requires the Activation of Multiple Accessory Pathways. Mol. Microbiol. 2020, 114, 377–390. [Google Scholar] [CrossRef]
- Grass, G.; Rensing, C.; Solioz, M. Metallic Copper as an Antimicrobial Surface. Appl. Environ. Microbiol. 2011, 77, 1541–1547. [Google Scholar] [CrossRef] [PubMed]
- Arendsen, L.P.; Thakar, R.; Sultan, A.H. The Use of Copper as an Antimicrobial Agent in Health Care, Including Obstetrics and Gynecology. Clin. Microbiol. Rev. 2019, 32, e00125-18. [Google Scholar] [CrossRef] [PubMed]
- Durán, N.; Durán, M.; de Jesus, M.B.; Seabra, A.B.; Fávaro, W.J.; Nakazato, G. Silver Nanoparticles: A New View on Mechanistic Aspects on Antimicrobial Activity. Nanomedicine 2016, 12, 789–799. [Google Scholar] [CrossRef] [PubMed]
- Borkow, G. Using Copper to Fight Microorganisms. Curr. Chem. Biol. 2012, 6, 93–103. [Google Scholar] [CrossRef]
- Hudzicki, J. Kirby-Bauer Disk Diffusion Susceptibility Test Protocol. Am. Soc. Microbiol. 2009, 15, 55–63. [Google Scholar]
- Vanek, D. An In-Depth Look at Selective Plating Processes: Brush, Anodizing, and Electropolishing. Metal. Finish. 2010, 108, 25–32. [Google Scholar] [CrossRef]
- Morris, J.C. Brush Plating. Metal. Finish. 1995, 93, 349–361. [Google Scholar] [CrossRef]
- Weber, S.; Liebelt, L.; Klier, J.; Pfeiffer, T.; Molter, D.; Ellrich, F.; Jonuscheit, J.; Freymann, G.V. Influence of System Performance on Layer Thickness Determination Using Terahertz Time-Domain Spectroscopy. J. Infrared Millim. Terahertz Waves 2020, 41, 438–449. [Google Scholar] [CrossRef]
- Lee, H.; Kim, J.; Lee, S.; Park, J.; Park, J.; Kim, J. Effect of Coating Thickness on Abrasion and Cutting Performance of NCD-Coated Ball Endmills on Graphite Machining. Micromachines 2023, 14, 664. [Google Scholar] [CrossRef]
Disclaimer/Publisher’s Note: The statements, opinions and data contained in all publications are solely those of the individual author(s) and contributor(s) and not of MDPI and/or the editor(s). MDPI and/or the editor(s) disclaim responsibility for any injury to people or property resulting from any ideas, methods, instructions or products referred to in the content. |
© 2023 by the authors. Licensee MDPI, Basel, Switzerland. This article is an open access article distributed under the terms and conditions of the Creative Commons Attribution (CC BY) license (https://creativecommons.org/licenses/by/4.0/).